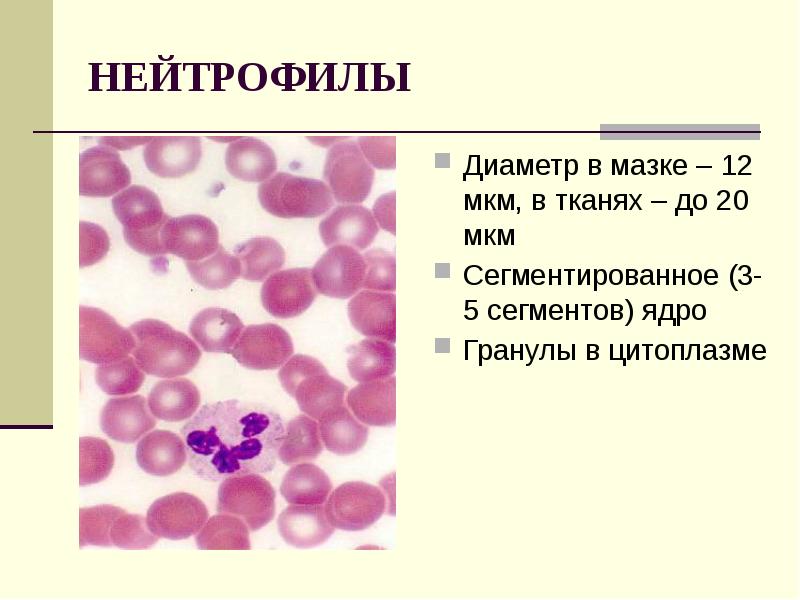

Лейкоциты п эр
Лейкоциты п эр 103 фото
Картинки с днем дарьи 1 апреля
Помни 15 русской
Чайка нижний новгород хоккей плей офф 2026
7 days to die боссы
Погода касли на 10 рп5
Опасно ли в подмосковье
Кинешма старая вичуга расписание автобусов
Основные категории первая категория это
Новый санпин по питанию в доу 2026
Огурцы надо закрывать